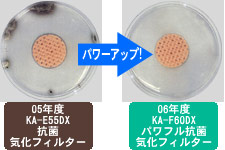

×
[PR]上記の広告は3ヶ月以上新規記事投稿のないブログに表示されています。新しい記事を書く事で広告が消えます。
カズヴィックス スチーム加湿器 ModelV105C
 風邪薬でおなじみのヴィックスの加湿器です。静音設計で約9時間連続運転が可能。
風邪薬でおなじみのヴィックスの加湿器です。静音設計で約9時間連続運転が可能。
噴出し口に安全ガードが付き、噴出し温度が下がったので一層安全になりました。
半クリアボディなので、残りの水量が一目でわかります。
のどの不快感を感じたら加湿器と一緒にリフレッシュ液も利用することで風の予防にもなります。花粉症対策にも効果的。

 リフレッシュ液使用方法:ヴィックス加湿器の噴出し口にリフレッシュ液を入れるくぼみに、約10ml(小スプーン2杯)程度のリフレッシュ液を入れるだけです。香りがなくなったらティッシュでふき取り、新たに液をたす。1回8時間の使用が目安です。
リフレッシュ液使用方法:ヴィックス加湿器の噴出し口にリフレッシュ液を入れるくぼみに、約10ml(小スプーン2杯)程度のリフレッシュ液を入れるだけです。香りがなくなったらティッシュでふき取り、新たに液をたす。1回8時間の使用が目安です。
噴出し口に安全ガードが付き、噴出し温度が下がったので一層安全になりました。
半クリアボディなので、残りの水量が一目でわかります。
のどの不快感を感じたら加湿器と一緒にリフレッシュ液も利用することで風の予防にもなります。花粉症対策にも効果的。
東芝 ハイブリット式加湿器 KA-F60DX

適用床面積の目安 木造和室:10畳まで、プレハブ洋室:17畳まで
湿度と温度の2つのセンサーで室温に合わせた快適湿度を自動コントロール。赤ちゃんのデリケートなお肌をいたわるやさしいうるおいをキープ。
●フラボノイドエアフィルター搭載
イチョウ葉エキスを加工したエアフィルターを搭載。ダニの死がいや花粉、ウィルス、雑菌などの働きを抑えます。
●パワフル抗菌気化フィルター目詰まりしにくい構造の抗菌気化フィルターの防カビ性能をさらにパワーアップ。カビの発生を抑えてキレイな加湿を実現します。
●噴出し面積が広いからさわっても熱くないのでやけどの心配がありません。
清潔の為の機能と、使いやすさの為の機能が充実している加湿器です。
適用床面積の目安 木造和室:10畳まで、プレハブ洋室:17畳まで
湿度と温度の2つのセンサーで室温に合わせた快適湿度を自動コントロール。赤ちゃんのデリケートなお肌をいたわるやさしいうるおいをキープ。
●フラボノイドエアフィルター搭載
イチョウ葉エキスを加工したエアフィルターを搭載。ダニの死がいや花粉、ウィルス、雑菌などの働きを抑えます。
●パワフル抗菌気化フィルター目詰まりしにくい構造の抗菌気化フィルターの防カビ性能をさらにパワーアップ。カビの発生を抑えてキレイな加湿を実現します。
●噴出し面積が広いからさわっても熱くないのでやけどの心配がありません。
清潔の為の機能と、使いやすさの為の機能が充実している加湿器です。
インターネット限定通販で高品質ソファーを激安販売
ウレタン素材で人気のソファーが1万5000円。安心安全の国内生産で、すべて受注生産なのもポイント。新生活にぴったりの激安・高品質ソファー。手ごろなサイズ・リーズナブルな価格なのに、ちゃんとスプリングコイルも入っていて品質に自信アリです。インターネット限定通販の高品質ソファーなら「ソファー通販 和み生活」で。激安ですよ!
カテゴリー
フリーエリア
カレンダー
| 03 | 2026/04 | 05 |
| S | M | T | W | T | F | S |
|---|---|---|---|---|---|---|
| 1 | 2 | 3 | 4 | |||
| 5 | 6 | 7 | 8 | 9 | 10 | 11 |
| 12 | 13 | 14 | 15 | 16 | 17 | 18 |
| 19 | 20 | 21 | 22 | 23 | 24 | 25 |
| 26 | 27 | 28 | 29 | 30 |
最古記事
(09/20)
(09/20)
(09/23)
(09/23)
(09/24)
最新記事
(09/26)
(09/26)
(09/26)
(09/26)
(09/26)
最新コメント
[09/03 ccccc]
[05/31 조건]
[05/31 조건]
[05/30 조건]
[05/24 조건]
最新トラックバック
ブログ内検索
